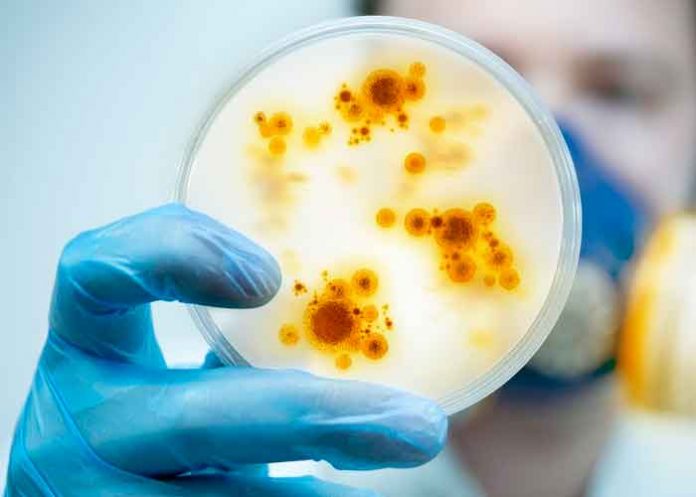
ciencia, virus, china, descubrimiento, estudio

Un grupo de científicos dedicado al estudio de hielo glaciar descubrieron virus de casi 15.000 años de antigüedad en dos muestras tomadas en una meseta tibetana en China.
Microbios y virus

El estudio publicado en la revista Microbiome revela microbios y virus diferentes a cualquier otro identificado hasta la fecha y que han sobrevivido durante años tras permanecer congelados. Los resultados de la investigación podrían permitir a los científicos entender mejor la evolución de los virus durante los siglos.
El equipo de investigadores creó un nuevo método ultra limpio de análisis de este tipo de microorganismos en hielo para no contaminar las muestras.
«Estos glaciares se formaron gradualmente, y junto con el polvo y los gases, muchos, muchos virus también se depositaron en ese hielo», explicó Zhi-Ping Zhong.
Análisis realizados
Los expertos analizaron núcleos de hielo tomados de la cima de Guliya, a 6.705 metros sobre el nivel del mar, en el oeste de China, en 2015. Las muestras contienen capas de hielo que se acumulan año tras año, atrapando todo lo que estaba en la atmósfera a su alrededor en el momento en que se congeló cada capa.

Mediante una combinación de técnicas de datación nuevas y tradicionales, los científicos determinaron la edad del núcleo de hielo tomado como muestra.
Durante el análisis encontraron códigos genéticos de 33 virus, cuatro de los cuales ya habían sido identificados anteriormente; sin embargo, al menos 28 de ellos son nuevos.
El análisis de los investigadores; basándose tanto en el medio ambiente como en las bases de datos de virus conocidos, mostró que los virus probablemente se originaron en el suelo o las plantas, no en los animales o los seres humanos.

Por su parte; Lonnie Thompson, uno de los principales autores del artículo, mencionó que el estudio de los virus en los glaciares es relativamente nuevo, pero es un área de la ciencia que se está volviendo más importante a medida que cambia el clima.